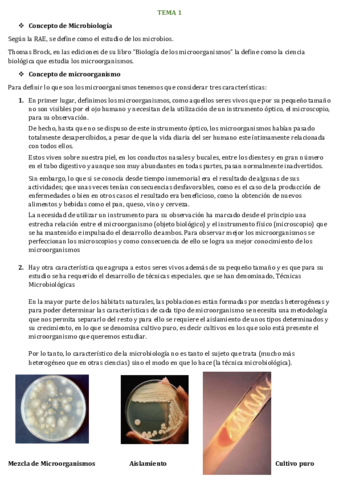

@patricuenca
61 Publicaciones
824 Interacciones
0 Seguidores
0 Siguiendo
Lista de publicaciones de patricuenca
apuntes
-
DERMOFARMACIA TEMAS 1-17
He publicado nuevos apuntes de 4º Dermofarmacia y Productos Sanitarios: DERMOFARMACIA TEMAS 1-17
apuntes
-
GALÉNICA segundo parcial
He publicado nuevos apuntes de 3º Farmacia Galénica I: GALÉNICA segundo parcial
apuntes
-
Microbiología
He publicado nuevos apuntes de 2º MICROBIOLOGIA, PARASITOLOGIA Y VIROLOGIA: Microbiología